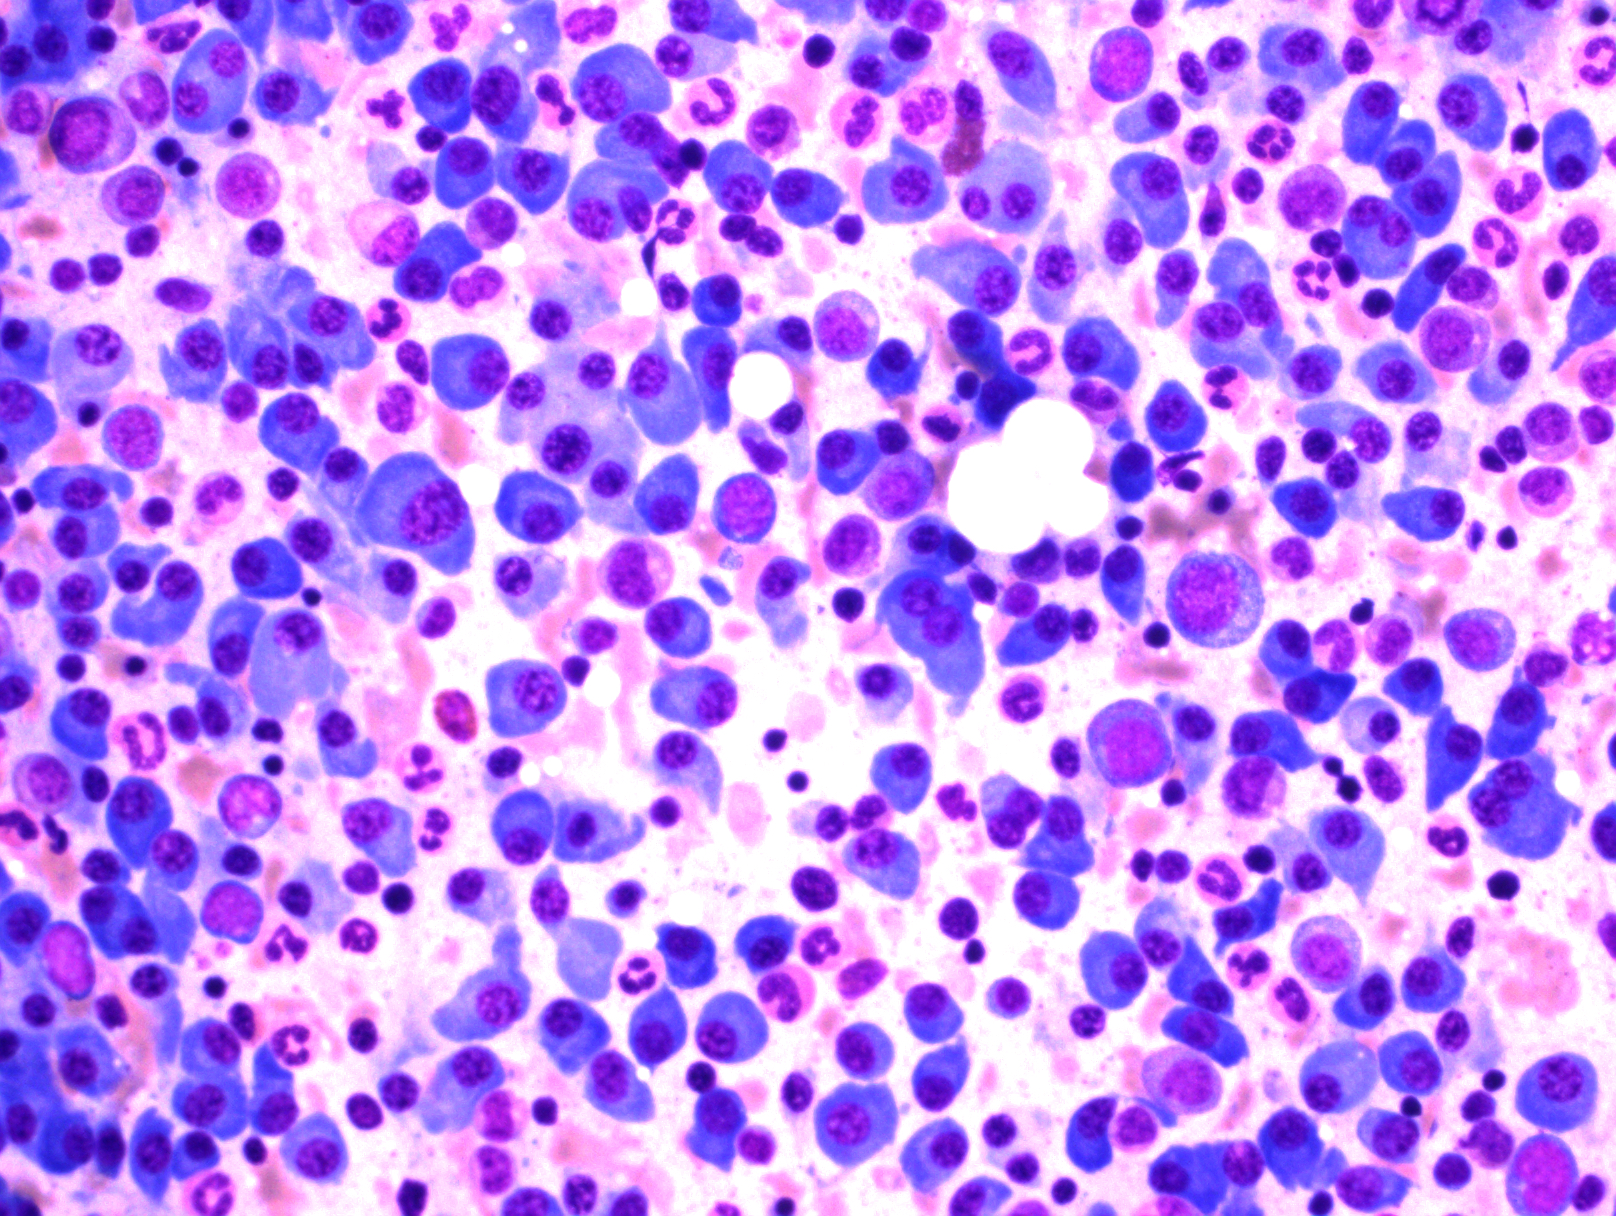
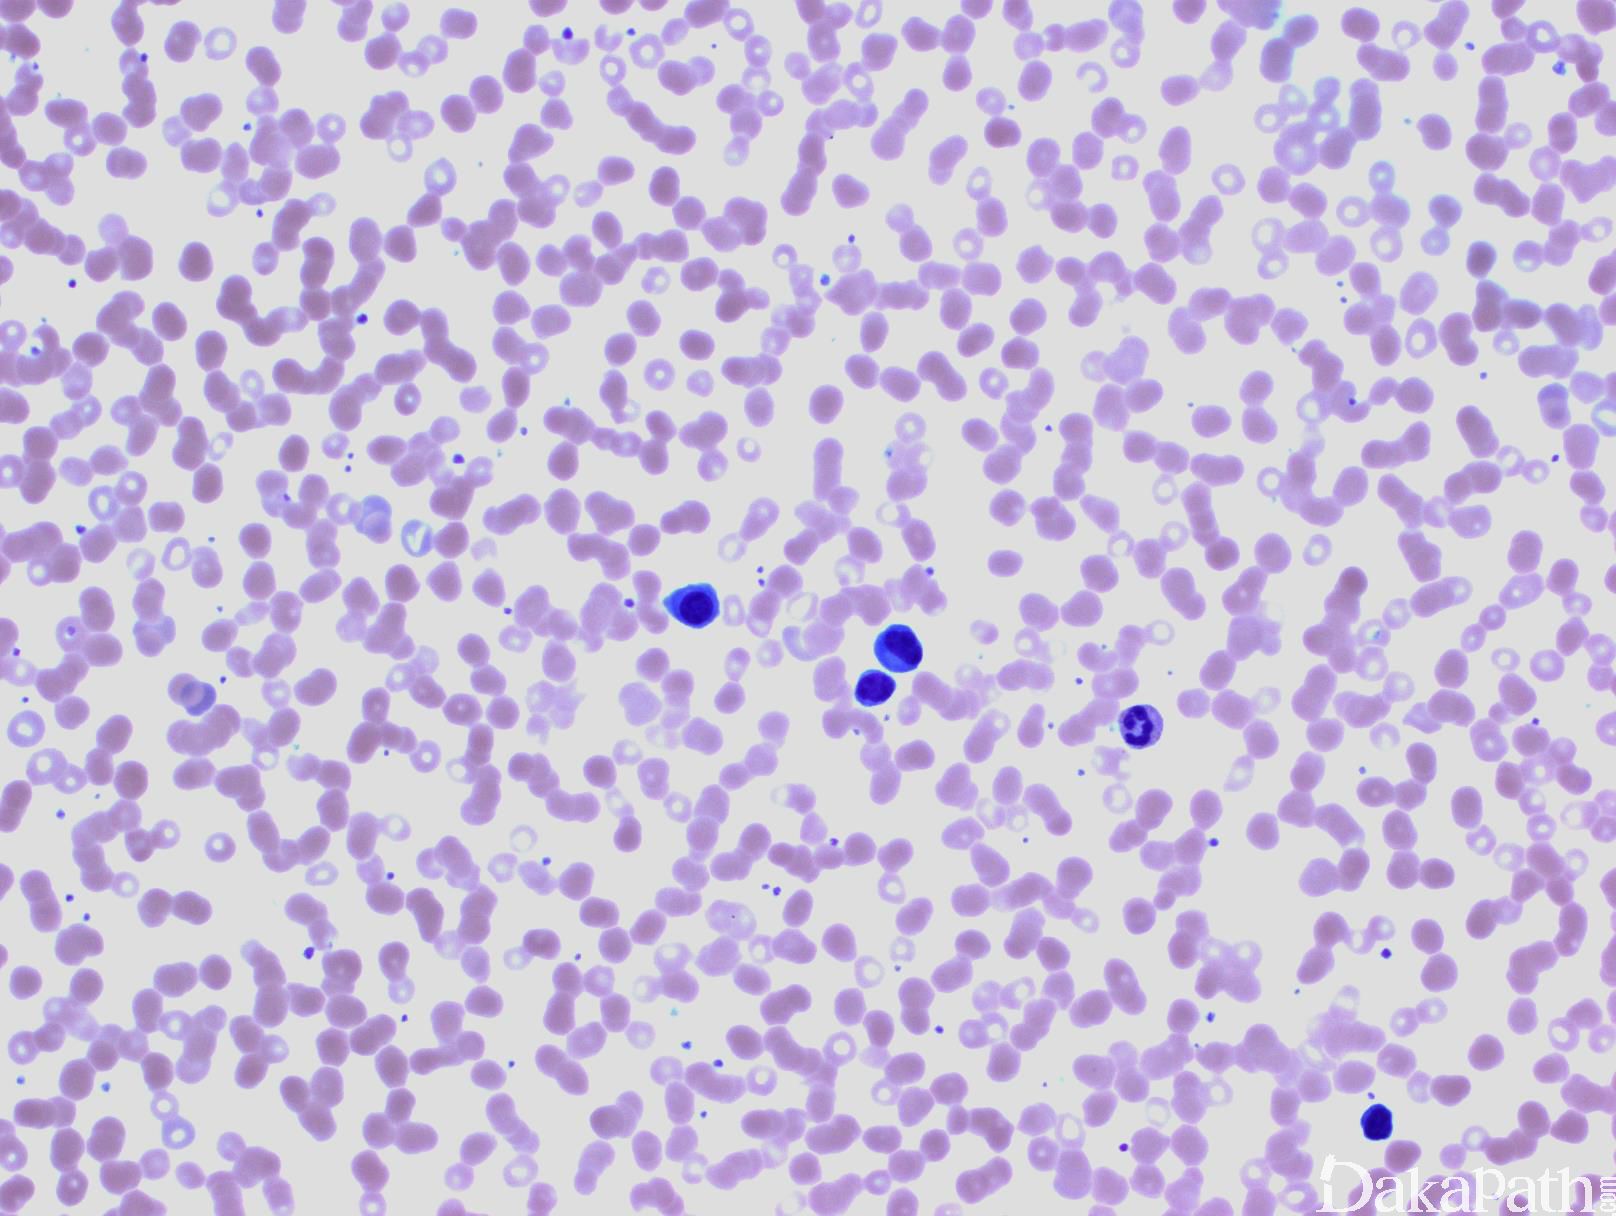

浆细胞骨髓瘤
Plasma Cell Myeloma, PCM
同义词(或曾用名): 多发性骨髓瘤(Multiple Myeloma)
概述:
浆细胞骨髓瘤是原发于骨髓的多灶性浆细胞肿瘤,伴血清和尿中单克隆蛋白。多数病例骨髓广泛受侵犯,其他器官也可继发受累。临床表现从无症状到高度侵袭性。有的症状系由异常免疫球蛋白链在组织中沉积所致。诊断 PCM 需综合临床、形态、免疫学以及影像学的发现。
诊断要点:
中位发病年龄 70 岁,30 岁以前很少见,儿童几乎从不发病。症状性浆细胞瘤表现为骨骼疼痛、贫血、乏力、肾功能损害和感染等。
诊断标准:克隆性骨髓浆细胞增多至少达 10%,或活检证实存在聚集成实性片状的浆细胞肿瘤,并出现下列至少一项与骨髓瘤相关的情况:
与浆细胞增生性疾病有关的终末器官损害:
- 高钙血症:血清钙比正常值上限高出 0.25mmol/L 以上(1mg/dL 以上)或高于 2.75mmol/L(11mg/dL)
- 肾功能不全:肌酐清除率小于每分钟 40ml 或血清肌酐高于 177µmol/L(高于 2mg/dL)/L
- 贫血:血红蛋白低于正常值 20g/L 以上或血红蛋白低于 100g/L
- 骨病变:至少有一处溶骨性病变(骨骼 X 线,CT 或 PET/CT)
至少有下列一项恶性肿瘤生物标记:
- 克隆性骨髓浆细胞至少 60%
- 血清非正常和正常轻链之比至少 100
- MRI 显示至少有一处病变
根据疾病的不同阶段,骨髓浆细胞浸润方式可以表现为间质性、局灶性或弥漫性浸润。一般浆细胞数达骨髓容量 30%,浆细胞骨髓瘤可能性很大。
肿瘤浆细胞形态变化很大,可以是成熟性、中间性、不成熟性、浆母细胞性或多形性。小细胞型则类似淋巴浆细胞,容易误诊为 LPL 或套细胞淋巴瘤。
浆细胞表达 CD138. 胞浆内 kappa 或 lambda,但无限制性表面轻链。CD19 和 CD20 一般阴性,但少数病例 CD20 有表达或部分表达。有些病例 cyclin D1+, 多见于类似淋巴浆细胞样形态的浆细胞骨髓瘤。异常表达的抗原(正常浆细胞不表达或仅少数细胞表达)有:CD56(见于 75-80%病例)、CD200(60-75%)、CD28(40%)、KIT(20-35%)、CD20(10-20%)。
血清或尿存在单克隆蛋白(97%病例),多数病例 IgG>30g/L、IgA>20g/L 或尿轻链>1g/24 小时(有些症状性 PCM 患者 M 蛋白低于上述水平),90%病例多克隆 Ig 降低(小于正常值 50%以下)。
影像学:至少 70%病例有骨病变,多数为溶骨性病变,有的为表现为病例性骨折或椎体压缩性骨折,或骨质疏松。
遗传学/FISH:约 1/3 病例细胞遗传学检测异常,多于 90%病例 FISH 检测异常。
临床亚型:
无症状(焖燃型)PCM-无相关的终末器官损害或组织损害,但其它均符合 PCM 诊断标准。
无症状(焖燃型)PCM :需同时符合下列两项诊断标准:血清单克隆蛋白(IgG 或 IgA)至少 30g/L 或尿蛋白每 24 小时至少 500mg,或/和克隆性骨髓浆细胞达 10-60%;(2)无相关的终末器官损害或组织损害,无淀粉样物质沉积症。临床表现类似 MGUS,但进展成症状型 PCM 可能性大得多,多数病例骨髓浆细胞数 10-20%,单克隆蛋白接近 3g/L。对于浆细胞超过 60%、游离异常轻链比超过 100,或有 2 处以上骨病变的病例,即使无上述(2),为及时治疗,也应该诊断为 PCM。
无分泌型 PCM : 此型罕见(占 PCM 的 1%)。肿瘤性浆细胞缺乏分泌或产生 Ig 能力,免疫固定分析无血清或尿 M 蛋白。但绝大多数病例中,免疫组化可测得胞浆内单克隆轻链,约 2/3 患者可检测到血清游离轻链水平升高或游离轻链比例异常。无分泌性 PCM 的细胞学和组织学特征、和遗传学特点与其他类型 PCM 类似。
浆细胞白血病(Plasma Cell Leukemia, PCL ) :外周血中肿瘤性浆细胞数>20%白细胞总数,或浆细胞绝对计数>2.0×109/L。多数 PCL 病例(60-70%)为原发(占所有 PCM 病例的 2-4%),中位发病年龄较轻。少数由 PCM 进展而来(占所有 PCM 病例 1%)。骨髓通常广泛或弥漫浸润,也累及其它脏器。免疫表型上与 PCM 同,但多数病例 CD56 阴性。临床表现为侵袭性,预后不良,生存期短。

鉴别诊断:
- MGUS : 血清存在低浓度单克隆蛋白(IgG<3g/dL,IgA<2g/dL,尿中无或很少克隆蛋白),骨髓浆细胞<10%(散在分布),无终末器官损害或组织损害。
- 反应性浆细胞增生 :见于感染、自身免疫疾病等。血清和尿中无克隆蛋白,免疫分型骨髓浆细胞为多克隆。
- 淋巴浆细胞淋巴瘤 :由浆细胞和 B 淋巴细胞组成,免疫分型两者都表达限制性轻链。血清存在克隆 IgM(IgM 浆细胞骨髓瘤罕见)。MYD88 基因突变阳性。
- 浆母细胞淋巴瘤 :侵犯骨髓时其形态及免疫分型与浆母细胞骨髓瘤相似,但有髓外病变和免疫缺陷(如 HIV)病史,且 EBER+。
← 血管内大B细胞淋巴瘤 Gamma重链病 →
